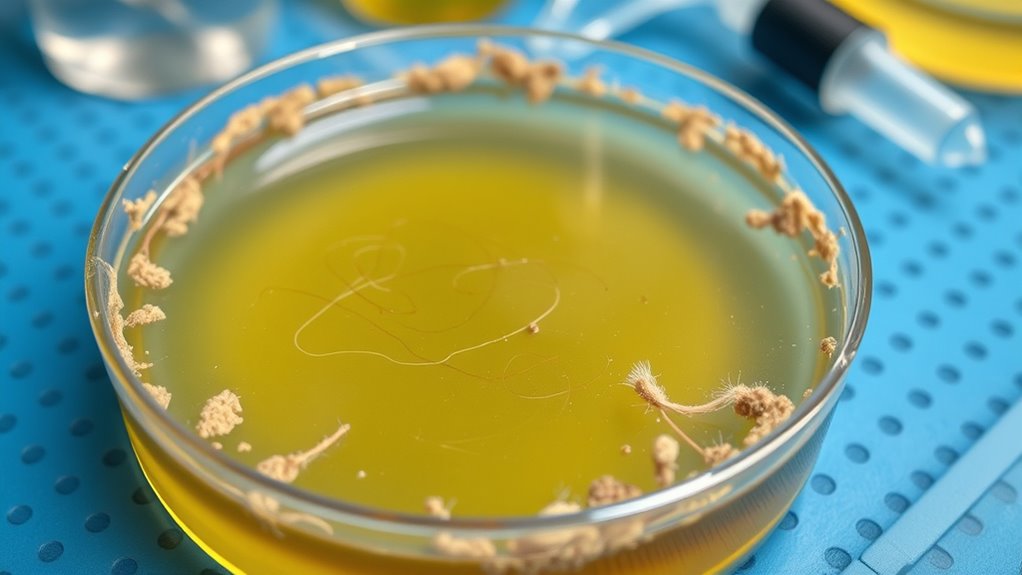
microbial biofilms cause odors

To identify taste and odor issues, focus on microbial activity, organic decay, and metal leaching from pipes. Microbes and biofilms produce earthy, musty, or foul tastes, while decay releases sulfur gases and acids. Metal leaching, especially iron and manganese, can cause metallic tastes or odors. Chemical contaminants and VOCs also contribute, often from industrial sources or aging plumbing materials. Understanding these causes helps you target solutions—continue to explore these key sources for more effective tips.
Key Takeaways
- Microbial activity and biofilms in pipes produce earthy, musty, or foul tastes and odors in water.
- Organic waste and decomposition release sulfur gases and acids that cause unpleasant flavors.
- Metal leaching from aging pipes, especially iron and manganese, can lead to metallic tastes and earthy odors.
- Residual disinfectants like chlorine interact with organic matter, creating chemical-like tastes and odors.
- External factors such as temperature, sunlight, and land use influence microbial growth and chemical reactions affecting water flavor.
Common Microbial Sources of Taste and Odor
Microbial activity is a primary cause of taste and odor issues in water systems. When microbes colonize surfaces, they form biofilm, a slimy layer that protects them and promotes growth. Biofilm formation is a common microbial source contributing to these problems because it harbors bacteria that produce off-odors and undesirable flavors. As microbes thrive within the biofilm, they release compounds like geosmin and methylisoborneol, which are responsible for earthy or musty tastes. Microbial colonization often occurs in pipes, storage tanks, and filters, making it a persistent challenge. Regular cleaning and disinfection help control biofilm buildup, reducing the likelihood of microbial activity causing noticeable taste and odor issues in your water system. Additionally, incorporating advanced filtration technology can help capture and reduce these microbial contaminants more effectively.
Organic Material and Decomposition Effects

Organic decay releases compounds that can alter taste and odor, especially when waste accumulates. Microbial activity accelerates decomposition, producing byproducts that affect water quality. Understanding these processes helps you identify and manage sources of unwanted tastes and odors. Additionally, vetted portable toilets are designed to minimize odor and facilitate easy cleanup, effectively managing waste in outdoor settings.
Organic Decay Processes
When organic materials break down, they release a variety of compounds that can substantially influence taste and odor. These compounds form through different biodegradation pathways, shaping the specific flavors and smells you encounter. Organic matter accumulation provides a constant source for microbial activity, accelerating decay processes. During decomposition, microbes break down complex molecules into simpler substances, producing volatile compounds like sulfur-based gases or organic acids. Understanding these pathways helps identify the source of unpleasant tastes or odors. The table below summarizes key compounds and their origins:
| Compound | Source | Impact on Taste/Odor |
|---|---|---|
| Hydrogen sulfide | Anaerobic microbial activity | Rotten egg smell |
| Organic acids | Organic matter breakdown | Sour taste, pungency |
| Ammonia | Protein decomposition | Sharp, pungent odor |
Additionally, recognizing microbial activity plays a crucial role in how these compounds are generated and how odor and taste profiles develop during decay.
Impact of Waste Accumulation
Waste accumulation, especially of organic materials, substantially influences the development of taste and odor issues. When waste buildup occurs, sediment accumulation in pipes or tanks creates a breeding ground for foul compounds. As organic material decomposes, it releases gases and soluble substances that can seep into water, causing undesirable tastes and smells. This buildup can trap sediments, leading to stagnant zones where odors intensify. Over time, the increased sediment accumulation can hinder proper flow and promote further waste retention. Managing waste buildup is essential to prevent these issues, as it directly impacts water quality and system performance. Regular cleaning and removal of organic debris help minimize sediment accumulation, reducing the potential for offensive taste and odor problems caused by organic material decomposition. Additionally, understanding the decomposition process is crucial for implementing effective maintenance strategies.
Microbial Activity Role
The decomposition process that occurs within waste buildup is driven primarily by microbial activity. Microbes break down organic material, releasing compounds that can produce taste and odor issues. During this process, biofilm formation often occurs on surfaces, creating protective layers that harbor microbes. These biofilms make microbial resistance more likely, enabling bacteria to survive disinfection efforts and prolonging odor problems. As microbes decompose organic matter, they produce gases and compounds responsible for foul tastes and smells. Understanding this activity helps you identify how microbial populations sustain odor sources. Managing biofilm formation through proper cleaning and disinfection can reduce microbial resistance, cutting down decomposition-related odors. Recognizing this microbial resistance role of microbial activity allows you to develop more effective strategies for controlling taste and odor issues caused by organic material breakdown.
Chlorine and Disinfectant Residuals

Residual chlorine can impact your water’s taste and smell, making it noticeable even at low levels. You need to monitor disinfectant levels carefully to prevent over-chlorination while ensuring safety. Finding the right balance helps control unpleasant odors without compromising water quality. Embracing a creative practice approach can help utilities develop innovative strategies for managing chlorination levels effectively.
Residuals and Taste
Although disinfectant residuals like chlorine are essential for maintaining water safety, they can also influence taste and odor. Residual effects from chlorine and other disinfectants may introduce taste contaminants that affect your water’s flavor. To understand this better, consider these points:
- Residuals can react with organic matter, creating taste contaminants.
- Over-chlorination intensifies residual effects, making water taste chemical-like.
- Low levels of residuals may still cause subtle taste issues.
- Removing residuals through aeration or activated carbon can improve taste quality.
- The presence of disinfectant residuals can also lead to the formation of disinfection byproducts, which may further impact water taste and safety.
These residuals often cause undesirable changes in flavor, making water seem off-putting. Recognizing the link between disinfectant residuals and taste helps you identify potential sources of taste contaminants and work toward better water quality.
Disinfectant Levels Control
Controlling disinfectant levels, especially chlorine, is crucial for maintaining water safety without compromising taste and odor. Proper control strategies help keep disinfectant residuals within ideal ranges, ensuring effective pathogen inactivation while preventing overpowering flavors. To assist, monitor free chlorine and combined residuals regularly, adjusting dosages as needed. Consider factors like contact time, water temperature, and organic matter that affect disinfectant stability. Use this table to understand control measures:
| Control Strategy | Purpose |
|---|---|
| Regular testing | Detect fluctuations in disinfectant levels |
| Adjusting chlorination rates | Maintain residuals within safe limits |
| Organic matter removal | Reduce disinfectant demand |
Maintaining optimal disinfectant levels also involves understanding disinfectant demand, which influences how much chlorination is necessary. Implementing these control strategies ensures safe, well-balanced water quality.
Balancing Chlorine Odors
Maintaining the right balance of chlorine odors is key to guaranteeing water remains both safe and palatable. Too much chlorine residuals can cause a strong odor, while too little may compromise disinfection. To manage this, focus on these aspects:
- Adjust chlorine residuals carefully to avoid overpowering smell.
- Use activated carbon filters to absorb excess chlorine and reduce odors.
- Monitor metal interactions, especially with iron and copper, which can intensify chlorine odors.
- Regularly test water to maintain ideal residual levels and prevent off-tastes.
- Incorporate advanced control systems to optimize chlorine dosing and improve overall water quality management.
Balancing chlorine odors involves controlling residuals and understanding metal interactions. Proper adjustment ensures disinfection without sacrificing water quality, keeping it fresh and safe for consumption.
Iron, Manganese, and Other Metals

Iron, manganese, and other metals are common sources of taste and odor issues in water supplies. These metals often enter water through metal leaching from pipes or fixtures, especially when water is acidic or has high mineral content. Mineral deposits from natural sources can also contribute to elevated metal levels, leading to a metallic taste or earthy odor. As these metals accumulate, they can cause discoloration and crust buildup in plumbing systems. Detecting these metals usually involves water testing for iron, manganese, and other trace elements. To address these issues, you might need filtration systems designed to remove metals or adjust water chemistry to prevent metal leaching. Regular maintenance and monitoring help keep your water tasting fresh and free of metallic odors. Understanding the metal leaching process can further assist in preventing contamination at its source.
Volatile Organic Compounds (VOCs) in Water

Volatile Organic Compounds (VOCs) in water can cause taste and odor problems that are often hard to detect without testing. These compounds can enter water through various sources, releasing volatile emissions that affect quality. To understand and address VOCs, consider these points:
- VOCs originate from chemical absorption in industrial processes or household products.
- They readily volatilize, making their emissions detectable by smell or taste.
- Testing involves specialized methods to identify specific VOCs present.
- Removing VOCs often requires activated carbon filters or aeration to reduce volatile emissions effectively.
Plumbing Materials and Aging Infrastructure

As water travels through aging or deteriorating plumbing systems, the materials used in pipes and fixtures can considerably influence water quality. Pipe corrosion is a common issue, especially when incompatible materials react over time, releasing metals or other substances that affect taste and odor. For example, incompatible material combinations can accelerate corrosion, causing metallic tastes or foul smells. Older pipes made of galvanized steel or certain plastics may degrade, leading to buildup and leaks that introduce contaminants. Ensuring material compatibility when replacing plumbing is essential to prevent these problems. Regular inspections help identify early signs of deterioration. Upgrading to corrosion-resistant materials, like copper or PEX, can minimize taste and odor issues caused by aging infrastructure, keeping your water fresher and safer.
Environmental Factors Influencing Taste and Odor

Environmental factors such as temperature, sunlight, and surrounding land use can considerably influence the taste and odor of your water. These factors can trigger chemical interactions and physical disturbances that alter water quality. For example,:
- Elevated temperatures accelerate microbial activity, producing odorous compounds.
- Sunlight causes photochemical reactions, affecting taste and odor molecules.
- Land use, like agriculture or industry, introduces chemicals that interact with water components.
- Physical disturbances, such as heavy rainfall or construction, disturb sediments and release odors.
These influences change water chemistry and physical makeup, making odors more noticeable. Understanding how these environmental factors interact with your water helps you anticipate changes and develop better management strategies. Recognizing these influences enables you to address taste and odor issues more effectively.
Quick Testing Techniques to Identify Causes

Quick testing techniques can help you identify the sources of taste and odor issues rapidly without the need for complex laboratory analysis. Start with simple field tests, like checking for pH fluctuations, which can signal changes in water chemistry linked to contamination. If pH levels are outside normal ranges, it may indicate aquifer contamination affecting water quality. Use inexpensive test strips to measure pH, odor, and other parameters like chlorine or iron levels. Observe any unusual taste or smell alongside these readings. If you notice a sudden change, it could point to contamination sources or natural shifts in the aquifer. These quick tests enable you to narrow down potential causes, whether it’s aquifer contamination or chemical imbalances, so you can take appropriate action faster.
Frequently Asked Questions
How Can Taste and Odor Issues Be Prevented Before They Start?
To prevent taste and odor issues, focus on source prevention by maintaining clean water systems and regularly inspecting equipment. Implement early detection methods like routine testing and monitoring to catch problems before they worsen. You should also address potential sources proactively, such as removing biofilms or controlling chemical levels, ensuring issues don’t develop. Staying vigilant and acting quickly helps keep taste and odor problems from starting, saving time and resources down the line.
Are There Long-Term Health Effects From Common Taste and Odor Compounds?
You might wonder if long-term health effects from common taste and odor compounds exist. While most are safe at low levels, certain chemicals can cause health issues through chemical interactions or promote microbial growth, leading to potential harm over time. Continuous exposure to specific compounds might result in allergic reactions or other health concerns. It’s wise to monitor and control these substances to minimize risks and protect your well-being.
What Are the Most Cost-Effective Methods for Ongoing Odor Control?
You can save money by combining ozone treatment and carbon filtration for ongoing odor control. Ozone treatment quickly neutralizes odors at the source, while carbon filters absorb lingering smells and improve air quality over time. Regular maintenance of these systems guarantees their effectiveness and longevity. Using these methods together offers a cost-effective, efficient solution that reduces ongoing expenses and keeps your environment fresh and odor-free.
How Do Seasonal Changes Impact Water Taste and Odor?
You’ll notice seasonal algae and temperature fluctuations turn your water into a flavor rollercoaster. As temperatures rise or fall, algae blooms spike, creating more taste and odor issues. Warm months usually bring stronger odors, while cold spells might mute flavors temporarily. So, when seasons change, expect your water’s taste and odor to follow suit—sometimes delightfully, sometimes not—making you wish for a trusty water filter that laughs in the face of nature’s whims.
Can Taste and Odor Problems Indicate Larger Water Quality Issues?
Yes, taste and odor problems can signal larger water quality issues. They often point to microbial growth or chemical reactions that water treatment might not fully address. If you notice persistent tastes or odors, it’s a sign to investigate further, as these issues could indicate contamination or inadequate filtration. Addressing the root cause guarantees safer, cleaner water and prevents potential health risks associated with poor water quality.
Conclusion
Understanding the sources of taste and odor in water helps you troubleshoot effectively. By recognizing microbial, chemical, and environmental factors, you can take targeted action to improve water quality. Quick tests and awareness of plumbing and infrastructure issues make detection easier. So, next time your water’s off-taste or smell bothers you, won’t it be reassuring to know you have the knowledge to identify and address the cause quickly?